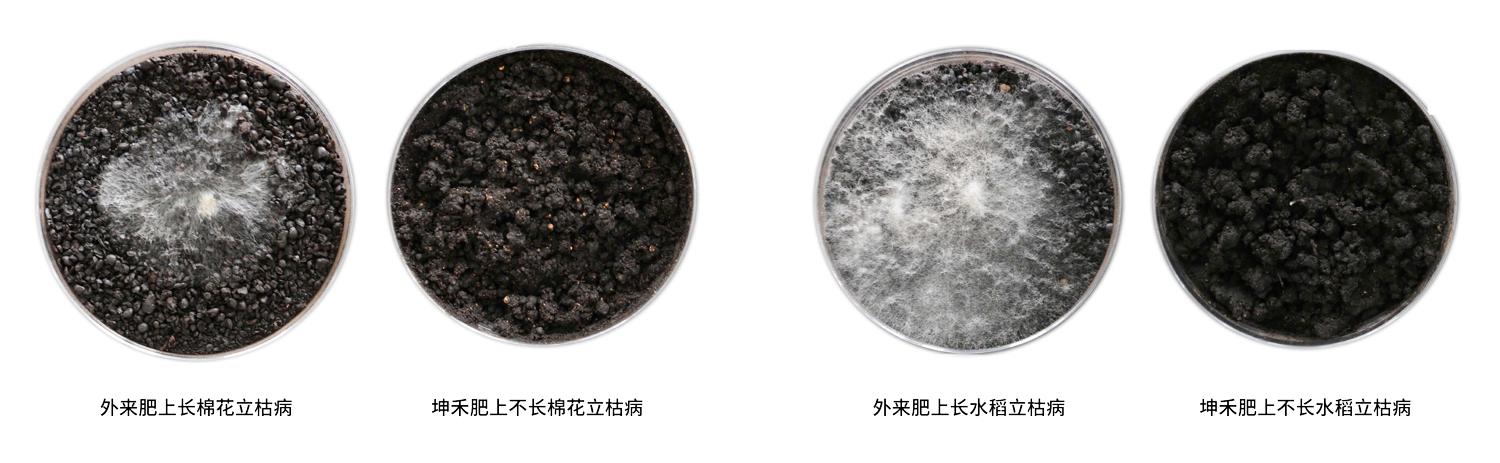
病原菌試驗-01.png

2023年7月22日—23日��,由《農(nóng)資導(dǎo)報》與中化化肥聯(lián)合發(fā)起,天津坤禾生物科技集團(tuán)股份有限公司(以下簡稱“坤禾集團(tuán)”)、諾穩(wěn)薩集團(tuán)��、北京金必來生物科技有限公司����、意大利比奧齊姆聯(lián)合主辦的2023中國生物農(nóng)業(yè)推進(jìn)大會在山東臨沂重磅召開。
進(jìn)入新時期�����,農(nóng)業(yè)高效可持續(xù)發(fā)展必須依賴科技創(chuàng)新變革�����。生物技術(shù)由此走進(jìn)行業(yè)視野�����,成為農(nóng)資行業(yè)新一輪轉(zhuǎn)型升級的引擎之一��,前景非常廣闊����。與會代表指出,發(fā)展生物農(nóng)業(yè)��,這既是國家戰(zhàn)略的頂層設(shè)計,也是全球農(nóng)業(yè)競爭的新高地�����,中國農(nóng)資行業(yè)理應(yīng)迎頭趕上��。
中國生物農(nóng)業(yè)推進(jìn)大會是《農(nóng)資導(dǎo)報》年度重磅活動中國生物農(nóng)業(yè)推進(jìn)大行動中的重要一環(huán)�����。本次會議同步舉行了中國生物農(nóng)業(yè)推進(jìn)大行動啟動儀式��。坤禾集團(tuán)董事長唐廣輝�����、總經(jīng)理兼技術(shù)總監(jiān)趙鋼勇����、營銷總監(jiān)韓志文�、北方區(qū)域營銷總監(jiān)陳保華、魯蘇區(qū)域經(jīng)理齊述強����、微生態(tài)事業(yè)部總經(jīng)理張得軍等工作人員與同行企業(yè)大咖出席本次會議,相聚大會,共同見證�����。

▲坤禾集團(tuán)董事長唐廣輝(右二)
坤禾集團(tuán)主要聚焦于土壤微生態(tài)�。坤禾集團(tuán)總經(jīng)理兼技術(shù)總監(jiān)趙鋼勇指出,現(xiàn)代農(nóng)業(yè)敗也微生物���,成也微生物���。只有微生物間科學(xué)協(xié)同才能發(fā)揮更大的作用,因此坤禾集團(tuán)的微生物農(nóng)法總結(jié)了坤禾六組肥的規(guī)劃��,包括打好底��、提苗壯枝梢�、壯花穩(wěn)果、育幼果�����、膨好果����、增糖上色�,按照農(nóng)作物生長的物侯期去設(shè)計開發(fā)專用肥料����,助力種植者種出好品質(zhì)。

在國家大力倡導(dǎo):“化肥農(nóng)藥雙減” ���、“有機(jī)肥替代化肥”�、“強化土壤污染管控和修復(fù)�����,加強農(nóng)業(yè)面污染防治”等農(nóng)業(yè)政策的引導(dǎo)下����,天津坤禾集團(tuán)秉承“還原生態(tài)����,健康中國”的企業(yè)愿景,基于獨有的功能菌群篩選和科學(xué)配伍�,經(jīng)過基礎(chǔ)研究、產(chǎn)品研發(fā)�����、育苗實驗、質(zhì)量檢驗等層層把關(guān)��,推出安全��、高效的產(chǎn)品��。具有代表性的產(chǎn)品有很多��,比如腐熟蛋白生物有機(jī)肥��,采用專用菌種進(jìn)行定向腐熟����,形成植物病原菌不容易分解利用和生長繁殖的特殊微生物菌蛋白——腐殖質(zhì)復(fù)合體,阻斷常見病原菌食物鏈��。
腐熟半成品和產(chǎn)品質(zhì)量檢驗特別增加生物學(xué)安全性檢測:1. 絲狀病原菌適生性檢測��。2. 選用小胚乳的裸子植物和被子植物的種子����。3. 驗證相對發(fā)芽指數(shù)和苗期相對發(fā)病指數(shù)。
坤禾集團(tuán)生產(chǎn)的系列農(nóng)用微生物肥料產(chǎn)品�����,著力提高腐熟蛋白有機(jī)養(yǎng)分和安全性,阻斷土壤植物病原菌食物鏈��,調(diào)理土壤酸堿鹽度���,修復(fù)和持續(xù)強化植物生長健康微生態(tài)系統(tǒng)和土壤有機(jī)無機(jī)養(yǎng)分循環(huán)的功能菌系統(tǒng)���,提高植物病原菌拮抗能力,促進(jìn)植物根系健康發(fā)達(dá)���,以解決植物營養(yǎng)吸收障礙�����。
坤禾集團(tuán)菌劑產(chǎn)品采用獨有的微生物細(xì)胞休止與激活技術(shù)���,包裝不帶孔。通過CMP技術(shù)減少細(xì)胞能量物質(zhì)交換和酶促反應(yīng)��,實現(xiàn)功能菌在桶內(nèi)儲運過程中以芽孢休眠體形態(tài)穩(wěn)定保存��、不萌發(fā)生長繁殖��、不惡臭脹氣�����、脹桶����,在施肥前用水稀釋150倍以上即可充分解除CMP控制,激活休眠體在適溫下高活性萌發(fā)��、大量生長繁殖�����,保證大量有效菌在根際發(fā)揮功效���。保質(zhì)期階段內(nèi)保證產(chǎn)品活菌性�,通俗點來說就是我們的產(chǎn)品在保質(zhì)期內(nèi)任何時間菌活禁得住相關(guān)權(quán)威部門的專業(yè)檢測�����,一直以來我們所追求的就是產(chǎn)品質(zhì)量嚴(yán)格化�����、產(chǎn)品研發(fā)專業(yè)化���,而現(xiàn)實是我們已經(jīng)做到了�。

本次會議,坤禾集團(tuán)在展位展示了以獨特自主技術(shù)和工藝開發(fā)的農(nóng)用系列微生物肥料產(chǎn)品����、系列工業(yè)級微生態(tài)功能菌原料產(chǎn)品以及公司雄厚的全產(chǎn)品鏈先進(jìn)制造實力和行業(yè)領(lǐng)先的獨有技術(shù)。

▲全國農(nóng)業(yè)技術(shù)推廣服務(wù)中心首席專家高祥照到訪坤禾集團(tuán)展位參觀交流

坤禾集團(tuán)吸引了眾多行業(yè)領(lǐng)導(dǎo)�����、專家��、企業(yè)代表駐足觀看與咨詢洽談�,而工作人員也始終以飽滿的熱情、耐心地與參展者溝通��,產(chǎn)品的特色和優(yōu)勢在工作人員細(xì)致的介紹下展現(xiàn)得淋漓盡致�,取得了非常好的反響。
到場參觀的客戶對坤禾集團(tuán)工作人員熱情周到的服務(wù)��、優(yōu)質(zhì)的產(chǎn)品品質(zhì)�����、“眼見為實”的產(chǎn)品應(yīng)用效果點贊��,紛紛表示希望能夠通過此次會議�����,能夠進(jìn)一步深入交流合作�����。最后��,感謝各界朋友對坤禾集團(tuán)參展此次生物農(nóng)業(yè)推薦大會的支持��,我們將延續(xù)精彩�����,期待與大家攜手為保障農(nóng)業(yè)產(chǎn)業(yè)安全����、農(nóng)產(chǎn)品質(zhì)量安全和生態(tài)環(huán)境安全做出應(yīng)有貢獻(xiàn)。